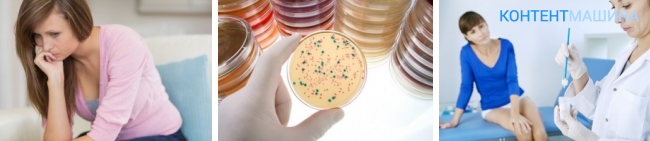

Достоверность результатов биопсии
Достоверность гистологического исследования превышает 90%. Его положительный результат служит основанием для постановки окончательного диагноза и назначения схемы лечения, в том числе проведения операции по поводу онкологического заболевания.
Биопсию при подозрении на опухоль лучше делать в специализированных государственных медучреждениях, где работают опытные доктора и опытные патоморфологи. Это значительно снизит вероятность диагностической ошибки. Если результат гистологического исследования отрицательный, но у врача есть веские основания считать, что онкозаболевание у пациента все же имеется, проводятся повторные биопсии.
Цитологическое исследование является методом скрининговой (промежуточной) диагностики. Его результаты в значительной степени зависят от количества материала и его сохранности, а также от того, насколько прицельно он взят. Если результат цитологического исследования положительный, то это служит основанием для проведения более сложного гистологического исследования.
Отрицательный результат не отвергает предполагаемый диагноз онкологического заболевания.
Как подготовиться к исследованию
Для неинвазивных методов цитологии особой подготовки не требуется. А вот для проведения биопсии, в том числе и для тонкоигольной, лучше быть натощак, поскольку забор материала будет проводиться инвазивно и скорее всего потребует обезболивания. То же касается эндоскопических методов исследования.
В ряде случаев на первом этапе проводят цитологическое исследование, выставляют предварительный диагноз, планируют лечение и объем операции. И уже инраоперационно, во время онкохирургического вмешательства берут биопсию. По ее результатам устанавливается окончательный диагноз и при необходимости проводится коррекция лечения.
Запись на консультацию круглосуточно
+7 (495) 668-82-28
Чем отличаются мазок на цитологию?
Цитология и ещё гистология являются одними из самых распространенных методов исследования патологий в организме. Такой вопрос, как чем цитология отличается, интересует многих, но прежде нужно сказать, что отличие цитологии заключается в том, что предметом её изучения являются живые ткани. То есть если при гистологии берется отдельный тканевый участок, то мазок на цитологию подразумевает изучение всех клеток, которые отработала шейка матки. Это основные отличия между гистологическими исследованиями.
Мазок на цитологию выполняется в целях получения сведений о недугах шейки матки или влагалищных нарушений.
Бывает, что мазка на цитологию бывает недостаточно для получения точной информации, тогда берется анализ крови. Здесь уже в дело может вступать гематология. Надо отметить, что анализ крови необходим, когда есть серьезные подозрения на раковые заболевания. Причем гематологический анализ может занять не мало времени.
Мазок на цитологию надо сдавать после того, как прекратились месячные. Если в организме есть сильные воспаления или период менструации, то мазок на цитологию не делается. За пару дней до такой процедуры, женщина должна прекратить вести сексуальную жизнь, недопустимо спринцевание и введение свечей, предназначенных для введения в вагину. Только после этого может делаться анализ на цитологию.
Такая процедура осуществляется так:
- пациента садится в кресло гинеколога, после чего доктор вводит ей во влагалище зеркало, которое позволяет получить доступ в каналу шейки матки;
- для мазка на цитологию используется шпатель специального назначения или специальная щеточка;
- после того, как врач произвел общий осмотр, мазок берется на месте, которое подвергнуто воспалению или просто подозрительно;
- материал, который получен таким способом, наносится на специальное стекло, после чего его можно внимательно изучать.
Вся эта процедура много времени не занимает, как правило на все уходит минут 15 и это включая гинекологический осмотр, так что в плане разницы во времени, то для цитологических исследований его требуется меньше.
ЛЕКЦИЯ О КРОВИ. НУЖНО ЗНАТЬ ВСЕМ!!!
Из чего состоит кровь
Цитология. Лекция 8. Митоз. Окштейн И.Л.
Строение ядра
B-лимфоциты и T-лимфоциты популяций CD4+ и CD8+
Нервная ткань. 6. Нервные волокна
Строение плазматической мембраны клетки
Что означает повышение лейкоцитов в анализе крови? – Доктор Комаровский
Зачетный тест по анатомии и гистологии. Коллоквиум по физиологии.
Анализ пункции
ЛЕКЦИЯ О КРОВИ. НУЖНО ЗНАТЬ ВСЕМ!!!
Из чего состоит кровь
Цитология. Лекция 8. Митоз. Окштейн И.Л.
Строение ядра
B-лимфоциты и T-лимфоциты популяций CD4+ и CD8+
Нервная ткань. 6. Нервные волокна
Строение плазматической мембраны клетки
Что означает повышение лейкоцитов в анализе крови? – Доктор Комаровский
Зачетный тест по анатомии и гистологии. Коллоквиум по физиологии.
Анализ пункции
Подготовка к забору материала
Мазок для цитологии шейки матки берут в определенный день менструального цикла. Лучше всего проходить эту процедуру за 4-5 дней до начала менструации или через 4-5 дней после ее окончания.
К процедуре нужно подготовиться. Женщине нужно:
Отказаться от использования вагинальных свечей, мазей и кремов, а также гигиенических тампонов за 2 дня до забора мазка. Также нельзя делать спринцевание.
- Отказаться от половых контактов за 1–2 дня до анализа.
- Не мочиться за 2–3 часа до исследования.
При назначении мазка на цитологию нужно проконсультироваться с врачом относительно необходимости отмены принимаемых препаратов.
Возможны ли ошибки при исследовании?
Есть 4 основных условия, которые могут повлиять на результаты гистологии.
- Врач, который проводит биопсию, должен сделать прицельный забор образца пораженной ткани с максимальной точностью – непосредственно из опухоли. Для этого применяют новейшие УЗИ-аппараты, позволяющие врачу визуально контролировать свои действия.
- Хранение и препарирование биообразцов должно соответствовать медицинским нормам. В идеале образец хранят так, чтобы его можно было использовать для повторного исследования.
- Само исследование должен проводить специалист с высокой квалификацией и многолетним опытом.
- Исследовательское оборудование должно быть высокого класса и обладать широким спектром технических возможностей.
Если все условия соблюдены, то риск ошибки сводится к нулю.
Особенности расшифровки цитологии: шкала по Бетесду
До недавнего времени результат анализа на цитологию содержал информацию о том, в какую из пяти цитологических групп была включена пациентка. Если у женщины была первая или вторая группа, результат был нормальным, третья, четвертая или пятая – плохим. В настоящее время гинекологические общества многих европейских стран рекомендуют описание исследования в соответствии с классификацией Bethesda.
Описание по Бетесду более подробное и содержит дополнительную информацию, важную, прежде всего, для врача
С точки зрения пациентки, ей важно знать, содержит ли мазок только клетки нормального эпителия, что означает результат «нормальный», или же в мазке присутствуют подозрительные или аномальные клетки, и женщине требуются дальнейшие анализы и лечение
Осложнения
Хотя гистологические исследования являются важным инструментом для диагностики и изучения заболеваний, они могут сопровождаться потенциальными осложнениями. Одним из основных рисков является возможность введения ошибок на различных этапах процесса подготовки образца. Например, неправильная фиксация тканей или их повреждение в ходе изготовления микроскопических срезов может привести к искажению результатов и, соответственно, ошибочной интерпретации данных.
Другим потенциальным осложнением является неспецифичность некоторых гистологических признаков, что может затруднить точную дифференциацию между различными заболеваниями
Это особенно важно в случаях, когда структурные изменения тканей не являются характерными или уникальными для конкретного патологического процесса
Кроме того, сами процедуры взятия биопсии или хирургического удаления тканей не лишены рисков для пациента, таких как кровотечение, инфекции или неприятные ощущения после процедуры. Необходимость внимательного наблюдения и профессиональной экспертизы важна для снижения возможных осложнений и обеспечения точности результатов гистологических исследований.
Показания для гистологии
- Определения природы новообразования (злокачественная или доброкачественная опухоль).
- Выявление причин бесплодия.
- Мониторинг состояния слизистой при хронических воспалительных процессах в ЖКТ, мочеполовой системе и других органах.
Преимущества метода — точное определение наличия патологических клеток. Для этого часто отбирают пробу на границе здоровых и пораженных тканей органа.
Как проходит процедура
Биоматериал забирают в ходе биопсии. Диагносты клиники «Имидж Лаб» используют различные способы:
- инцизионной — в ходе оперативного вмешательства забирается вся удаленная опухоль;
- щипково — с помощью эндоскопических щипцов откусывается часть новообразования;
- пункционно — толстая игла делает прокол и отбирает клетки из опухоли. Применяют для забора проб из печени и предстательной железы;
- аспирационно — специальная трубка отсасывает частичку полипа. Применяют при заборе проб из щитовидной железы, миоматозных новообразований;
- эксцизионно — удаленную опухоль, пораженный и соседние органы со следами прорастания рака отправляют на исследование;
- трепан-биопсия — взятие проб из костной ткани;
- кюрежат — соскабливание слизистых или эпидермиса;
- мазок — забор клеток слизистой оболочки специальной щеточкой.
Чтобы минимизировать риски для пациента биопсию проводят под контролем УЗИ, цифрового рентгена или С-дуги рентген аппарата. Для снятия болевых ощущений применяют местную анестезию или делают общий наркоз. Процедура занимает от пары минут до часа. Пациент не нуждается в госпитализации после биопсии.
Как проводят гистологию?
Препарат фиксируют веществом, блокирующим действие ферментов и разрушение тканей. Заливают дальше парафином для уплотнения. Специальный прибор нарезает полученные ткани на ломтики по 8 мм толщиной. Дальше окрашивают. Потом исследуют все образцы под микроскопом. Обычно результаты готовы за 7-10 дней. Для гистологии костей требуется не менее 14 дней.
В критических случаях проводят экспресс-диагностику. Например, если в ходе операции обнаружили опухоль. Тогда биопрепарат изымается, замораживается, нарезается специальным прибором и немедленно исследуется. Экспресс-гистология занимает до 1 часа
Поэтому важно, чтобы клиника имела собственную лабораторию, делающую анализы в ускоренном режиме. Подобная база есть в «Имидж Лаб». Это позволяет комплексно подходить к решению задач и оперативно начинать терапию пациента
Это позволяет комплексно подходить к решению задач и оперативно начинать терапию пациента.
Результаты и расшифровка анализа на гистологию
Клиент на руки получает письменное заключение. На бланке указаны ФИО больного, дата и место забора проб, тип тканей, которые отбирались.
Расшифровать его самостоятельно сложно. Поэтому доктора клиники «Имидж Лаб» и диагносты на приеме расскажут о дальнейших планах лечения и разработают курс терапии.
Именно гистология служит инструментом сверхранней диагностики онкологии и существенно увеличивает шансы на полное выздоровление от рака.
Что видит врач при проведении цитологии
Чтобы понять, какие клетки может увидеть врач при проведении цитологии, нужно представить строение эпителия – ткани, покрывающей шейку матки и цервикальный канал.
Многослойный плоский эпителий, покрывающий снаружи шейку матки, состоит из нескольких слоев:
- Базального и расположенного над ним парабазального. Эта ткань состоит из клеток, имеющих небольшой размер и крупное ядро – центральную часть клетки, в которой хранится генетическая информация.
- Сверху над парабазальным расположен промежуточный слой. Его клетки вытянутые (веретенообразные) с мелкими ядрами.
- Самый верхний слой называется поверхностным. Он состоит из крупных клеток с большими ядрами двух типов – пикнотичными (сморщенными) и везикулярными (пузырьковидными).
Цервикальный канал, проходящий внутри шейки матки, выстлан однослойным цилиндрическим (железистым) эпителием. Внутри него находятся железы, выделяющие слизь, которая смазывает слизистую.
В мазок во время взятия анализа попадают все виды клеток, но в разных отделах шейки они встречаются в различных количествах. Цитология также зависит от возраста женщины.

Цитологический скрининг
Диагностика
При помощи лабораторных исследований диагностировать экзо, эндоцервицит довольно просто.
Обычно используются следующие методы:
- анализ на цитологию;
- микроскопия мазка;
- бакпосев;
- определение рН выделяемой секреции;
- анализ ПЦР и иммуноферментный.
Также показана и кольпоскопия.
К обязательным исследованиям относят:
- микроскопию на флору из уретры, влагалища и цервикального канала;
- обязательно нужно исключить грибки, трихомонады, гонококки, гарднереллы;
- бакпосев проводят, чтобы определить чувствительность возбудителя цервицита к антибиотикам;
- мазок на цитологию, дабы исключить раковые клетки.
Для получения данных о состоянии всего организма проводят дополнительное обследование:
- ОАК;
- ОАМ;
- анализ крови на ВИЧ и сифилис;
- бакпосев на гонококк;
- определяют, нет ли инфекций, передающихся половым путем.
Кольпоскопия позволит обнаружить пораженные участки диаметром от 0,1 до 0,5 см. Они окрашены в желтовато-красный оттенок, а вокруг окружены каймой белого цвета. Такая клиника присуща воспалительному процессу.
Экзоцервицит, эндоцервицит — что это такое, всегда видно при помощи микроскопа. Поверхность шейки обычно имеет утонченные зоны с сосудами, подвергшимися деформации.
Бывает и так, что небольшие очаги сливаются в один огромный. В таком случае будут просвечивать петли сосудов, которые расширились. Кроме того, не исключены кровоточащие сосуды, встречающиеся по одиночке. Наблюдается также гиперемия как диффузная, так и очаговая.
Лабораторные методы:
Микроскопия. Данный метод поможет установить, какие микробы являются виновниками воспаления, а какие принадлежат к группе лактобактерий.
Бакпосев. Чтобы определить, к какому роду и виду относится тот или иной микроорганизм, проводят бактериологическое исследование. Также благодаря данному способу, как уже упоминалось ранее, можно определить чувствительность вируса к антибиотикам.
Цитология. Данный метод позволяет понять, насколько повреждены ткани на клеточном уровне, увидеть их структуру. Когда цитограмма соответствует экзоцервициту или эндоцервициту, специалист должен обязательно искать причину такого состояния. Кроме того, данный анализ поможет определить, насколько эффективным было лечение.
Теперь давайте обсудим особенности кольпоскопии. Расширенная кольпоскопия — это возможность увидеть воспалительный процесс, а также после лечения оценить, насколько терапия была эффективной.
Как известно, влагалищная секреция разнится в зависимости от того, какой микроорганизм попал в половые пути и активно там размножается. Или же это может быть буйствует местная условно-патогенная флора, для которой были созданы благоприятные условия для роста.
При увеличении слизистой доктор обнаружит изменения цилиндрического эпителия в виде красных точек, являющихся верхушками мелких сосудов.
Во время кольпоскопии пробу Шиллера проводят для того, чтобы увидеть, как меняется слизистая под воздействием йода или кислоты. При истинной эрозии можно обнаружить гнойный налет. Экзоцервицит и эндоцервицит выглядят как светлые точечные очаги, находящиеся на фоне коричневых тонов. Или же будут обнаружены йодонегативные зоны округлой формы.
Помимо кольпоскопии проводят также и ультразвуковое обследование органов малого таза, дабы оценить состояние всей репродуктивной системы.
Задача специалиста провести дифференцирование таких диагнозов, как эндоцервицит, экзоцервицит, эктопия, рак шейки матки, а также специфических цервицитов, вызванных туберкулезом, сифилисом, гонореей.
Преимущества гистологического исследования по сравнению с биопсией
Одним из основных преимуществ гистологического исследования является возможность получить информацию о структуре и составе тканей, их морфологических и функциональных особенностях. Это позволяет врачам исследовать клетки и ткани под микроскопом, выявлять нарушения в их структуре и функции, а также определять возможные причины этих нарушений. Таким образом, гистологическое исследование позволяет более точно диагностировать заболевания и назначать эффективное лечение.
Кроме того, гистологическое исследование позволяет проводить детальный анализ исследуемых тканей, выявлять наличие или отсутствие опухолей, определять их стадию развития и выявлять метастазы
Это особенно важно при диагностике онкологических заболеваний, так как гистологическое исследование позволяет точно определить тип опухоли и ее характеристики, что необходимо для разработки оптимальной стратегии лечения
Кроме того, гистологическое исследование предоставляет возможность сохранить образец ткани в виде гистологических срезов, которые можно использовать для последующих исследований. Это позволяет проводить дальнейшие исследования с целью выявления дополнительных изменений в тканях и продолжать мониторинг состояния пациента.
Таким образом, гистологическое исследование является необходимым и эффективным методом диагностики и изучения тканей человеческого организма. Оно позволяет получить максимально точную информацию о состоянии тканей, выявить нарушения в их структуре и функции, а также определить характеристики опухолей. Это делает гистологическое исследование одним из основных методов врачебной практики и позволяет повысить эффективность диагностики и лечения различных заболеваний.
Гистология, с другой стороны, является методом, который позволяет более детально исследовать структуру и состав тканей. Она основана на микроскопическом анализе образцов ткани, полученных в результате биопсии. Гистологический анализ позволяет выявить патологические изменения и определить степень и характер заболевания.
Выбор метода исследования должен быть обусловлен клинической ситуацией и целью исследования. Если целью является диагностика заболевания или выявление его прогрессирования, то предпочтительнее использовать гистологический анализ. В случае, когда требуется оперативное принятие решений или оценка эффективности лечения, биопсия может быть более приемлемым методом.
Несмотря на преимущества и ограничения каждого метода, современная медицина стремится к комплексному подходу, включающему использование как биопсии, так и гистологии. Использование обоих методов позволяет повысить точность диагностики и улучшить прогнозирование течения заболеваний.
Показания к проведению исследования
Причиной для назначения анализа могут стать боли внизу живота, ненормальный менструальный цикл, дискомфорт при сексе. Данный метод исследования используют при патологиях шейки матки, главного детородного органа. Своевременно проведенное обследование даст шанс начать терапию на ранних этапах развития болезни. В некоторых ситуациях мазок на гистологию позволяет избежать оперативного вмешательства. Диагностику шейки проводят при подозрении на наличие лейкоплакии, аномальных клеток, неровной поверхности тканей.
После проведения анализа можно обнаружить внематочную или замершую беременность, злокачественные или доброкачественные новообразования. Диагностика делается при хроническом воспалительном процессе в области эндометрия, ациклических маточных кровотечениях, гиперплазии, подозрении на рак слизистой оболочки матки. Исследование назначают при обнаружении полипа, миомы.
Методика проводится для выявления различных отклонений и патологий. Гистологический анализ – это исследование эндометрия, изучение структуры плода. Исследование позволяет изучить точное строение любой ткани. Диагностику назначают после выскабливания по разным показаниям, при любых отклонениях, выявленных путем обычного гинекологического осмотра репродуктивной системы женщины на кресле.
Этапы проведения гистологического исследования
Процесс гистологического исследования включает следующие этапы:
- взятие образцов: забор тканей для исследования производится методом биопсии, пункции, щипка, аспирации или кюретажа (в гинекологии);
- фиксация: образцы помещаются в гистологические кассеты фиксируют в специальном растворе, обычно формалине, чтобы предотвратить разложение клеток и сохранить структуру тканей;
- обезвоживание: взятый образец подвергается дегидратации для удаления влаги;
- микротомия: ткани помещают в парафин для придания им удобной формы с целью нарезки тонкими срезами с помощью микротома (специального инструмента). После образцы размещают на предметные стекла;
- окрашивание: срезы окрашивают специальными красителями в медицинском пластике или колбах, что позволяет выделить различные структуры и компоненты ткани;
- микроскопический анализ: подготовленные образцы исследуют под микроскопом, чтобы выявить и оценить структурные особенности ткани, а также подтвердить/опровергнуть наличие патологий;
- отчет морфолога: полученные данные анализируются и интерпретируются специалистами гистологами и морфологами, которые дают заключение о состоянии тканей и возможных заболеваниях.
Возможности гистологического исследования

Гистологическое исследование открывает перед врачами большие возможности. Оно позволяет определить патологические процессы, которые происходят в тканях – например, некроз (разрушение), воспаление или опухолевое разрастание.
При гистологическом исследовании хорошо видны патологически измененные клетки и тканевые фрагменты. Также этот метод позволяет предположить или подтвердить инфекционную природу поражения.
Любые процессы в тканях – гиперпластические или атрофические – будут хорошо видны под микроскопом
Также гистологическое исследование дает возможность увидеть преобразование нормальных клеток в атипичные, что крайне важно в диагностике и лечении злокачественных новообразований
Техника выполнения
Любой гистологический препарат изучается под микроскопом световым или электронным, это зависит от оснащённости лаборатории. Но в основном, конечно, изучается препарат (биоптат) под световым микроскопом.
Изучает и даёт заключение врач-гистолог или патологоанатом (патологоанатом – это не только работник морга, врачи этой специальности обязательно владеют техникой микроскопического исследования препарата!). Подготавливают препараты к исследованию лаборанты.
Чтобы гистологически исследовать ткань, нужны особые приготовления.
- Самое первое, что происходит – это забор материала (биоптата), изначально кусочек органа должен быть помещён в специальный раствор (формалина или спирта), это делается для фиксации ткани и для предотвращения различных гнилостных процессов.
- Затем биоптат заливают парафином (получатся плотный квадратик).
- Следующее – на специальном аппарате делают тонкие срезы, чтобы слои клеток не накладывались друг на друга, это улучшает качество препарата.
- Окрашивание препаратов. Для того чтобы изучить различные структуры или изменённые клетки, используются специальные красители.
- Ну и, в конце концов, для того чтобы препарат сохранялся дольше, происходит его дальнейшая специальная обработка.

Как проходит
Процесс гистологического исследования начинается с получения биологического материала, который может быть взят в ходе биопсии или хирургического вмешательства. Этот образец ткани затем подвергается специальной обработке, начиная с фиксации, которая предотвращает распад клеток и сохраняет структуру тканей. После фиксации ткань внедряется в парафин, что делает ее твердой и позволяет получить тонкие микроскопические срезы.
Следующим этапом является изготовление микроскопических срезов, которые могут быть толщиной всего несколько микрометров. Эти срезы затем окрашиваются специальными красителями, которые выявляют различные структурные элементы ткани под микроскопом. Такая окраска позволяет гистологам более детально изучать клеточные компоненты, ядра, и другие структуры.
После окончания процесса подготовки готовые препараты помещаются под микроскоп для детального анализа. Гистологи, обладая экспертными знаниями, изучают структуру тканей, выявляют аномалии и изменения, которые могут свидетельствовать о различных патологиях. Полученные результаты интерпретируются и используются для постановки диагноза и разработки плана лечения, если необходимо.
Чем отличаются мазок на цитологию?
Цитология и ещё гистология являются одними из самых распространенных методов исследования патологий в организме. Такой вопрос, как чем цитология отличается, интересует многих, но прежде нужно сказать, что отличие цитологии заключается в том, что предметом её изучения являются живые ткани. То есть если при гистологии берется отдельный тканевый участок, то мазок на цитологию подразумевает изучение всех клеток, которые отработала шейка матки. Это основные отличия между гистологическими исследованиями.
Мазок на цитологию выполняется в целях получения сведений о недугах шейки матки или влагалищных нарушений.
Бывает, что мазка на цитологию бывает недостаточно для получения точной информации, тогда берется анализ крови. Здесь уже в дело может вступать гематология. Надо отметить, что анализ крови необходим, когда есть серьезные подозрения на раковые заболевания. Причем гематологический анализ может занять не мало времени.
Мазок на цитологию надо сдавать после того, как прекратились месячные. Если в организме есть сильные воспаления или период менструации, то мазок на цитологию не делается. За пару дней до такой процедуры, женщина должна прекратить вести сексуальную жизнь, недопустимо спринцевание и введение свечей, предназначенных для введения в вагину. Только после этого может делаться анализ на цитологию.
Самое главное в начале — определить характер заболевания, насколько опухоль поражает орган, степень дифференцировки, есть ли инвазия. Люди далёкие от медицины часто задаются вопросом: «Гистология — что это такое в онкологии, для чего нужна и что показывает?». Вопрос интересный и довольно обширный, но мы постараемся на него ответить как можно понятнее.
Заключение
Гистологическое исследование состоит в анализе тканей, полученных при проводимом ранее обследовании. Такое исследование позволяет подтвердить или опровергнуть наличие заболеваний и точно разобраться в смысле диагноза. Гистология лучше цитологии по своей информативности. Ее результаты позволяют обнаружить новообразования и определить их место, стадию и тип, а также оценить динамику процесса заболевания.
Основная разница между цитологией и гистологией заключается в материале, который анализируется. Цитология исследует клетки, полученные из материала, собранного с поверхности шейки матки с помощью специального аппарата. Гистология же анализирует образец ткани, который берется биопсией.
Если врачом были обнаружены подозрительные изменения на цитологическом анализе, анализ исследования мог его подтвердить или опровергнуть. В случае необходимости дальнейшего разобраться в ситуации или при сложных диагностических вопросах, требуется гистологическое исследование.
Важно понять, что цитология и гистология являются дополняющими исследованиями. Цитология позволяет быстро обнаружить изменения в клетках шейки матки, а гистология даёт более полную информацию о состоянии тканей, выявляя характер и масштаб изменений
При проведении исследований в гинекологии важно иметь в виду преимущества обоих методов и принимать решение о назначении их комплексно, чтобы точно определить состояние, диагноз и дальнейшее лечение.